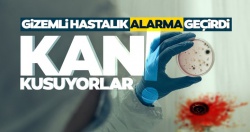
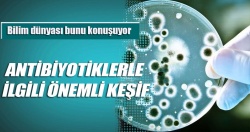

SAĞLIK
Her sabah 1 bardak kimyon suyu tüketin, vücuttaki yağları mum gibi eritin
21 Aralık 2024, Cumartesi

Kanserli hücrelerin oluşumunu engelliyor! Haftada birkaç defa yiyen şifa buluyor
19 Haziran 2022, Pazar
Kovid-19'dan daha büyük felaket geliyor!..
04 Temmuz 2020, Cumartesi